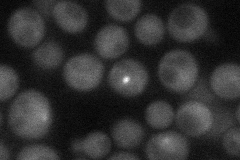
YOR073W

View description
Component of the spindle checkpoint, involved in sensing lack of tension on mitotic chromosomes; protects centromeric Rec8p at meiosis I; required for accurate chromosomal segregation at meiosis II and for mitotic chromosome stability
Localization:
Intensity:
Fold change:
Significance:
-
C’ GFP library in SD

punctate16.77 -
N' NOP1pr-GFP in SD
punctate34.007 -
N' TEF2pr-mCherry in SD

nucleus6.853 -
N' NATIVEpr-GFP in SD

below threshold19.1535 -
N' TEF2pr-VC and Cyto-VN in SD

#N/A0 -
C’ GFP library in SD+DTT

punctateN/AN/ANo -
C’ GFP library in SD+H2O2

punctateN/AN/ANo -
C’ GFP library in Starvation Media

punctateN/AN/AYes -
C’ GFP library on the background of Pup2-DaMP

punctate -
C’ GFP library on the background of CCT mutant

punctateN/AN/ANo
